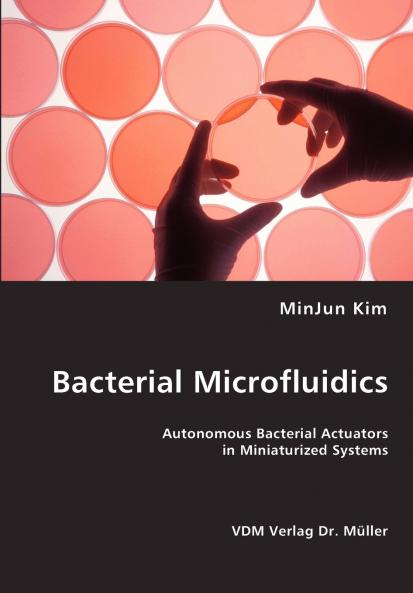
Bacterial Microfluidics

English
Paperback
₹6559
₹8450
22.38% OFF
(All inclusive*)
Delivery Options
Please enter pincode to check delivery time.
*COD & Shipping Charges may apply on certain items.
Review final details at checkout.
Looking to place a bulk order? SUBMIT DETAILS
About The Book
Description
Author
Microactuation systems are currently enabled only using large external appratus. This essentially defeats the original purpose of miniaturization. We employ flagellated bacteria as reconfigurable actuators in low Reynolds number fluidic environments. The bacteria are self-contained and are able to draw energy directly from the surrounding environment. Furthermore flagellated bacteria can be utilized as both individual microactuators and in arrays to create useful works in a variety of microfluidic environments and controlled in a directed manner using many different kinds of external stimuli such as temperature food and a specific wavelength of lights.The book is addressed to professionals in Science and Technology like fluid mechanicians microbiologists and nanoengineers. It is also directed towards researchers in Microfluidics Micro/Nanofabrication and Biophyics.
Delivery Options
Please enter pincode to check delivery time.
*COD & Shipping Charges may apply on certain items.
Review final details at checkout.
Details
ISBN 13
9783836435925
Publication Date
-04-03-2008
Pages
-116
Weight
-202 grams
Dimensions
-170x244x6.2 mm